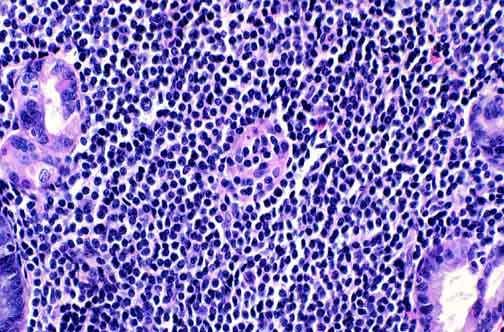

A low power view of a gastric maltoma. A clue to the malignant nature of this lymphoid infiltrate is its density and extent.
|
Focally the glands are invaded and destroyed by the lymphoid cells to produce a lymphoepithelial lesion, as seen here in the center. These lesions are particularly common in gastric maltomas.
|

A higher power view of a lymphoepithelial lesion. Note that most of the cells are about the size of benign small lymphocytes. Nuclear contour varies from oval to irregular to occasionally cleaved. Some cells in some cases may have modest amounts of cytoplasm keeping the nuclei are arm's length from each other. Such cells may be called "monocytoid".
|

Some lymphoepithelial lesions from another maltoma.
|


